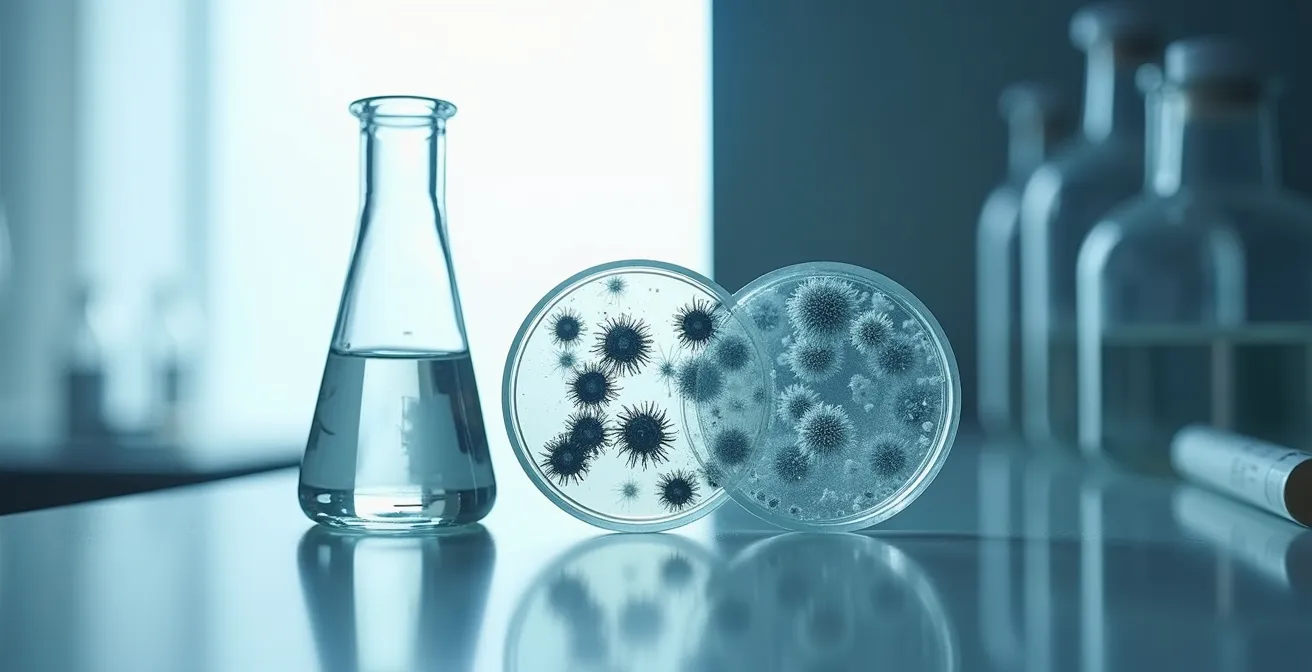

Entgegen der landläufigen Meinung ist nicht das Paraben in Ihrer Creme die grösste Bedrohung, sondern die unkonservierte Creme selbst.
- Das mikrobielle Risiko durch Keime in schlecht konservierten Produkten ist eine akute Gefahr für die Hautgesundheit.
- Voreilig verteufelte Inhaltsstoffe werden oft durch schlecht erforschte Alternativen ersetzt, die neue Probleme wie Allergiewellen verursachen können.
- Der Begriff „Clean Beauty“ ist nicht gesetzlich reguliert und dient oft als irreführendes Marketinginstrument.
Empfehlung: Bewerten Sie ein Kosmetikprodukt nicht anhand einer willkürlichen „schwarzen Liste“, sondern anhand seiner gesamten Formulierung, insbesondere des pH-Wertes und eines wissenschaftlich fundierten Konservierungssystems.
Sie stehen vor dem Kosmetikregal, umgeben von Etiketten, die schreien: „Frei von Parabenen“, „Clean Beauty“, „Ohne böse Chemie“. Ein Gefühl der Verunsicherung macht sich breit. Jahrelang wurde Ihnen erzählt, dass bestimmte Inhaltsstoffe, allen voran die Parabene, zu meiden sind. Sie gelten als hormonell wirksam, potenziell schädlich – als Feinde Ihrer Haut und Ihrer Gesundheit. Also greifen Sie zu dem Produkt, das mit seiner „Reinheit“ wirbt, und fühlen sich auf der sicheren Seite. Doch was wäre, wenn ich Ihnen als Toxikologe sage, dass diese gut gemeinte Entscheidung Sie einem viel grösseren, realeren Risiko aussetzen könnte?
Die moderne Kosmetikdebatte hat ein gefährliches Vakuum geschaffen: das Konservierungsvakuum. Durch die Dämonisierung von bewährten, wissenschaftlich umfassend untersuchten Konservierungsstoffen wie Methylparaben wurde ein Nährboden für zwei Probleme geschaffen. Erstens, die Gefahr der mikrobiellen Kontamination in Produkten, deren Haltbarkeitssystem unzureichend ist. Zweitens, der Aufstieg von neuen, weniger erprobten Alternativen, die sich manchmal als problematischer herausstellen als die Substanzen, die sie ersetzen sollten. Die Wahrheit ist komplexer als eine einfache Liste von „guten“ und „schlechten“ Inhaltsstoffen. Sie liegt im Formulierungskontext, in der Konzentration und vor allem in einer soliden Risiko-Nutzen-Abwägung.
Dieser Artikel führt Sie hinter die Kulissen der Marketing-Slogans und beleuchtet die wissenschaftlichen Fakten. Wir werden analysieren, warum eine schimmelige Creme eine unmittelbare Bedrohung darstellt, wie die panische Flucht vor Parabenen zu einer Allergiewelle führte und warum der pH-Wert Ihrer Hautpflege weitaus wichtiger ist als jedes „Bio“- oder „Clean“-Siegel. Es ist an der Zeit, die Angst durch Wissen zu ersetzen und fundierte Entscheidungen für die Gesundheit Ihrer Haut zu treffen.
Um diese komplexen Zusammenhänge zu entwirren, werden wir die wichtigsten Aspekte Schritt für Schritt beleuchten. Die folgende Übersicht gibt Ihnen einen klaren Fahrplan durch die Mythen und Fakten der modernen Hautpflege.
Inhaltsverzeichnis: Die Wahrheit über Konservierungsstoffe und Clean Beauty
- Warum eine schimmelige Creme gefährlicher für Sie ist als Methylparaben?
- Methylisothiazolinon (MI): Warum die Paraben-Alternative eine Allergiewelle auslöste?
- Marketing ohne Gesetz: Warum jeder seine Marke „Clean“ nennen darf?
- Guter Alkohol, schlechter Alkohol: Wann trocknet Ethanol aus und wann ist Fettalkohol pflegend?
- Warum „pH-Hautneutral“ wichtiger für die Verträglichkeit ist als „Bio“?
- Wie Alkohol und ätherische Öle in der Naturkosmetik die Haltbarkeit sichern?
- Warum ein pH-Wert von 5,5 für Ihre Haut überlebenswichtig ist?
- Kaputte Hautbarriere erkennen: Warum Ihre Haut brennt, egal was Sie auftragen?
Warum eine schimmelige Creme gefährlicher für Sie ist als Methylparaben?
In der öffentlichen Diskussion über Kosmetiksicherheit dominiert die Angst vor chemischen Inhaltsstoffen. Doch aus toxikologischer Sicht ist die grösste unmittelbare Gefahr nicht chemischer, sondern biologischer Natur: das mikrobielle Risiko. Eine Creme, ein Serum oder eine Lotion ist oft ein idealer Nährboden für Bakterien, Hefen und Schimmelpilze. Sobald Sie ein Produkt öffnen und mit den Fingern hineingreifen, beginnt der Wettlauf gegen die Kontamination. Ohne ein wirksames Konservierungssystem können sich diese Mikroorganismen explosionsartig vermehren.
Die Folgen sind weitreichend. Auf der Haut können kontaminierte Produkte zu Reizungen, Akne-Ausbrüchen, Infektionen und allergischen Reaktionen führen. Besonders gefährlich wird es bei Produkten, die in der Nähe der Augen oder auf verletzter Haut angewendet werden. Hier können Keime schwere Infektionen verursachen. Internationale Normen wie die ISO 18415:2007 existieren, weil diese Gefahr so real ist. Sie definieren, dass Kosmetika frei von bestimmten Krankheitserregern sein müssen. Zu den gefährlichsten gehören Pseudomonas aeruginosa, ein Bakterium, das für schwere Wund- und Lungeninfektionen bekannt ist, sowie Staphylococcus aureus, Escherichia coli und der Hefepilz Candida albicans. Wie die Normen zur mikrobiologischen Prüfung von Kosmetika festlegen, müssen Produkte gegen diese spezifischen Bedrohungen geschützt sein.
Diese mikroskopische Ansicht verdeutlicht, was in einem unzureichend konservierten Produkt passieren kann. Die leuchtenden Kolonien repräsentieren Bakterien, die sich in der cremigen Textur vermehren – eine unsichtbare, aber reale Bedrohung.

Parabene wie Methylparaben sind seit Jahrzehnten die effektivsten, am besten erforschten und verträglichsten Waffen gegen genau dieses Szenario. Sie bieten ein breites Wirkungsspektrum gegen eine Vielzahl von Keimen bei sehr geringen Konzentrationen. Die theoretische Sorge vor einer hormonellen Wirkung von Parabenen, die in relevanten Studien am Menschen nie nachgewiesen wurde, steht hier im krassen Gegensatz zum bewiesenen Risiko einer bakteriellen Infektion durch eine schlecht konservierte Creme. Die Risiko-Nutzen-Abwägung fällt hier eindeutig aus: Die Sicherheit vor einer nachgewiesenen Gefahr wie einer Hautinfektion wiegt schwerer als die Angst vor einem hypothetischen Risiko.
Methylisothiazolinon (MI): Warum die Paraben-Alternative eine Allergiewelle auslöste?
In den frühen 2000er Jahren, als die öffentliche Kritik an Parabenen zunahm, suchte die Kosmetikindustrie händeringend nach Alternativen. Einer der vielversprechendsten Kandidaten war ein Konservierungsmittel namens Methylisothiazolinon (MI). Es war hochwirksam und schien die perfekte Lösung zu sein, um dem Ruf nach „parabenfreien“ Produkten nachzukommen. Doch was als Triumph des Marketings begann, endete in einem dermatologischen Desaster und dient heute als Lehrbuchbeispiel für die unvorhergesehenen Folgen des „Konservierungsvakuums“.
Kurz nach der breiten Einführung von MI in abwaschbaren und auf der Haut verbleibenden Produkten schnellten die Zahlen der Kontaktallergien in die Höhe. Dermatologen auf der ganzen Welt meldeten eine regelrechte Epidemie von Patienten mit schweren allergischen Hautreaktionen: Rötungen, Juckreiz, Schwellungen und nässende Ekzeme. Die Ursache war fast immer MI. Das American Contact Dermatitis Society erklärte MI 2013 sogar zum „Allergen des Jahres“, um auf die dramatische Zunahme der Fälle aufmerksam zu machen.
Die wissenschaftlichen Daten untermauern dieses Phänomen eindrücklich. Eine in Nordamerika durchgeführte aktuelle Studie aus dem Jahr 2024 zeigt, dass fast 14 % der getesteten Patienten mit Verdacht auf Kontaktdermatitis positiv auf MI reagierten. Bei überwältigenden 97,4 % dieser Fälle wurde die Reaktion als klinisch relevant eingestuft, was bedeutet, dass der Inhaltsstoff tatsächlich die Symptome des Patienten verursachte. Diese Zahlen sind alarmierend hoch und übertreffen die Sensibilisierungsraten für Parabene bei Weitem, die im niedrigen einstelligen Bereich liegen und oft klinisch nicht relevant sind.
Die Geschichte von MI ist eine ernüchternde Lektion: Die Verteufelung eines gut erforschten Inhaltsstoffs (Parabene) führte zu dessen Ersatz durch einen weniger erforschten Inhaltsstoff mit einem viel höheren allergenen Potenzial. Die Industrie reagierte schliesslich und schränkte die Verwendung von MI, insbesondere in Leave-on-Produkten, drastisch ein. Doch der Schaden war bereits angerichtet und das Vertrauen der Verbraucher weiter erschüttert. Es zeigt, dass „neu“ und „frei von“ nicht automatisch „besser“ oder „sicherer“ bedeutet. Eine sorgfältige wissenschaftliche Prüfung über lange Zeiträume ist unerlässlich, bevor ein Inhaltsstoff breit eingesetzt wird.
Marketing ohne Gesetz: Warum jeder seine Marke „Clean“ nennen darf?
Der Begriff „Clean Beauty“ ist heute allgegenwärtig. Er suggeriert Reinheit, Sicherheit und Natürlichkeit. Verbraucher assoziieren damit Produkte, die frei von „giftigen“ oder „schädlichen“ Chemikalien sind. Das Problem? Es gibt keine rechtlich bindende Definition für „Clean Beauty“. Weder in Europa noch in den USA ist dieser Begriff durch eine Behörde reguliert. Jede Marke kann ihre eigene Definition aufstellen und ihre Produkte als „clean“ bewerben, solange sie nicht nachweislich falsche Gesundheitsaussagen trifft.
Diese regulatorische Lücke hat eine Goldgräberstimmung im Marketing ausgelöst. Oft bedeutet „clean“ lediglich, dass auf eine selbst definierte Liste von Inhaltsstoffen verzichtet wird – die sogenannten „No-Listen“. Diese Listen enthalten häufig Parabene, Sulfate, Silikone oder Mineralöl. Die Auswahl der verbannten Inhaltsstoffe folgt dabei selten einer wissenschaftlichen Logik, sondern orientiert sich an dem, was in der öffentlichen Meinung gerade als „böse“ gilt. So entsteht der irreführende Eindruck, dass Produkte ohne diese Inhaltsstoffe per se sicherer oder besser für die Haut wären, was, wie das MI-Beispiel zeigt, nicht der Fall sein muss.
Dieses Vorgehen ist eine Form des sogenannten „Greenwashing“ – der Versuch, einem Produkt durch gezieltes Marketing ein umweltfreundliches oder gesundes Image zu verleihen, ohne dass es dafür eine ausreichende Grundlage gibt. Das Ausmass dieser Praxis ist beträchtlich. Eine von der Europäischen Kommission unterstützte Untersuchung zeigt, dass 42 % der „grünen“ Werbeaussagen von Unternehmen übertrieben, falsch oder irreführend sind. Noch entlarvender ist, dass 58 % der befragten CEOs zugeben, dass ihre eigenen Unternehmen am Greenwashing beteiligt sind.
Für Sie als Verbraucher bedeutet das: Das „Clean“-Label ist kein verlässliches Gütesiegel für Sicherheit oder Qualität. Es ist in erster Linie ein leistungsstarkes Marketinginstrument, das mit Ihrer Angst und Ihrem Wunsch nach Sicherheit spielt. Anstatt blind einem „Clean“-Versprechen zu vertrauen, ist es sinnvoller, sich auf nachprüfbare Fakten zu konzentrieren: eine transparente INCI-Liste, dermatologische Testergebnisse und das Verständnis für die Funktion jedes Inhaltsstoffs im Formulierungskontext. Ein Produkt ist nicht gut, weil etwas fehlt, sondern weil das, was enthalten ist, sinnvoll und wirksam zusammengestellt wurde.
Guter Alkohol, schlechter Alkohol: Wann trocknet Ethanol aus und wann ist Fettalkohol pflegend?
Alkohol ist ein weiterer Inhaltsstoff, der oft pauschal verteufelt wird. Die Aussage „Alkohol trocknet die Haut aus“ ist jedoch eine unzulässige Vereinfachung. In der Kosmetikchemie gibt es eine ganze Familie von Alkoholen mit völlig unterschiedlichen Eigenschaften und Funktionen. Die Unterscheidung zwischen „guten“ und „schlechten“ Alkoholen ist entscheidend für das Verständnis einer Produktformulierung.
Der „schlechte“ Alkohol, auf den sich die meisten Warnungen beziehen, ist Ethanol, der in INCI-Listen oft als „Alcohol“ oder „Alcohol Denat.“ (denaturierter Alkohol) deklariert ist. In hohen Konzentrationen hat Ethanol tatsächlich eine austrocknende und potenziell reizende Wirkung. Er entzieht der Haut Lipide (Fette) und kann so die Hautbarriere schwächen. Er wird oft als Lösungsmittel, zur Konservierung oder zur Verbesserung der Textur eingesetzt. Steht er ganz vorne in der INCI-Liste, ist bei trockener oder empfindlicher Haut Vorsicht geboten.
Auf der anderen Seite stehen die „guten“ Alkohole, die sogenannten Fettalkohole. Dazu gehören Substanzen wie Cetyl Alcohol, Stearyl Alcohol oder Cetearyl Alcohol. Chemisch gesehen sind sie völlig anders aufgebaut als Ethanol. Es handelt sich um wachsartige, feste Substanzen, die aus pflanzlichen Fetten gewonnen werden. Anstatt die Haut auszutrocknen, haben sie pflegende Eigenschaften. Sie wirken als Emollienzien (machen die Haut weich und geschmeidig), als Verdickungsmittel (geben Cremes ihre reichhaltige Textur) und als Emulgatoren (verbinden Wasser und Öl). Sie sind ein wertvoller und unproblematischer Bestandteil vieler Feuchtigkeitscremes und Conditioner.
Die pauschale Ablehnung von Produkten „mit Alkohol“ ist also nicht sinnvoll. Es kommt auf die Art des Alkohols, seine Konzentration und die Gesamtformulierung an. Eine kleine Menge Ethanol in einem ansonsten reichhaltigen Produkt mit vielen pflegenden Ölen und Feuchthaltemitteln ist meist unproblematisch. Ein Produkt, das hauptsächlich aus Wasser und Ethanol besteht, ist hingegen kritischer zu sehen.
Ihr Aktionsplan: Alkohole in der INCI-Liste richtig deuten
- Position überprüfen: Wenn ‚Alcohol Denat.‘ oder ‚Ethanol‘ unter den ersten drei Inhaltsstoffen steht, könnte das Produkt potenziell austrocknend wirken.
- Pflegende Alkohole identifizieren: Suchen Sie nach Cetyl Alcohol, Stearyl Alcohol und Cetearyl Alcohol. Dies sind pflegende Fettalkohole, die die Haut geschmeidig machen.
- Kompensierende Inhaltsstoffe erkennen: Prüfen Sie, ob die Formulierung ausgleichende Stoffe wie Glycerin, Hyaluronsäure, Öle oder Butter enthält, die einer austrocknenden Wirkung entgegenwirken.
- Vorsicht bei „konservierungsmittelfrei“: Einige „konservierungsmittelfreie“ Produkte nutzen Alkohol in sehr hoher Konzentration als alleiniges Konservierungssystem, was die Hautbarriere belasten kann.
- Ausgewogenheit bewerten: Ein gutes Produkt zeichnet sich durch eine intelligente Balance aus, bei der alle Inhaltsstoffe im richtigen Verhältnis zueinander stehen, um Wirksamkeit und Verträglichkeit zu gewährleisten.
Warum „pH-Hautneutral“ wichtiger für die Verträglichkeit ist als „Bio“?
Das „Bio“-Siegel auf einem Kosmetikprodukt suggeriert Natürlichkeit und Sanftheit. Doch für die unmittelbare Gesundheit und Verträglichkeit Ihrer Haut ist ein anderer, oft übersehener Faktor weitaus entscheidender: der pH-Wert. Die Hautoberfläche ist von Natur aus leicht sauer, mit einem durchschnittlichen pH-Wert von etwa 5,5. Dieser sogenannte Säureschutzmantel ist eine fundamentale Verteidigungslinie. Er hemmt das Wachstum schädlicher Bakterien und unterstützt das hauteigene Mikrobiom sowie essenzielle enzymatische Prozesse.
Wird dieser saure pH-Wert gestört, gerät das gesamte Ökosystem der Haut aus dem Gleichgewicht. Produkte mit einem hohen, also alkalischen pH-Wert (über 7), können den Säureschutzmantel regelrecht abwaschen. Dies schwächt die Hautbarriere, führt zu Feuchtigkeitsverlust und macht die Haut anfälliger für Trockenheit, Reizungen und Infektionen. Es schafft zudem ein Milieu, in dem sich unerwünschte Keime wie Staphylococcus aureus, ein Verursacher von Hautinfektionen und Ekzem-Schüben, wohler fühlen als nützliche Bakterien wie Staphylococcus epidermidis.
Genau hier liegt das Problem vieler traditionell hergestellter „Bio“-Produkte, insbesondere klassischer Seifenstücke. Eine durch Verseifung von Fetten hergestellte Seife ist von Natur aus alkalisch und hat typischerweise einen pH-Wert zwischen 8 und 10. Auch wenn die verwendeten Öle aus biologischem Anbau stammen, greift der hohe pH-Wert bei jeder Anwendung den Säureschutzmantel an. Ein synthetisch hergestelltes Waschstück (Syndet) mit einem auf 5,5 eingestellten pH-Wert ist aus dermatologischer Sicht daher oft die sanftere und verträglichere Wahl, auch wenn es nicht „bio“ ist.
Die folgende Tabelle verdeutlicht den direkten Einfluss des pH-Wertes verschiedener Produkte auf die Hautbarriere und das Mikrobiom.
| Art des Produkts | Durchschnittlicher pH-Wert | Einfluss auf die Hautbarriere | Effekt auf das Mikrobiom |
|---|---|---|---|
| Bio-Seife (verseift) | 8-10 | Störung des Säureschutzmantels | Fördert pathogenen S. aureus |
| Synthetischer Reiniger (pH 5.5) | 5-5.5 | Erhält die Barrierefunktion | Fördert schützenden S. epidermidis |
| Kalkhaltiges Leitungswasser | 7.5-8.5 | Progressive Austrocknung | Mikrobielles Ungleichgewicht |
Die Verträglichkeit eines Produkts hängt also weniger von der Herkunft seiner Inhaltsstoffe (bio vs. synthetisch) ab, sondern vielmehr von seiner physiologischen Kompatibilität mit der Haut. Ein hautneutraler pH-Wert ist eine der wichtigsten Grundlagen für eine gesunde Hautbarriere und sollte bei der Produktauswahl, insbesondere bei Reinigungsprodukten, ein zentrales Kriterium sein.
Wie Alkohol und ätherische Öle in der Naturkosmetik die Haltbarkeit sichern?
Wenn zertifizierte Naturkosmetik auf synthetische Konservierungsstoffe wie Parabene verzichtet, wie stellt sie dann sicher, dass die Produkte nicht innerhalb weniger Tage verkeimen? Die Antwort liegt in einer Kombination aus cleverer Formulierung und dem Einsatz von Substanzen, die neben ihrer Hauptfunktion auch eine antimikrobielle Wirkung besitzen. Die beiden wichtigsten Akteure in diesem System sind Alkohol (Ethanol) und ätherische Öle.
Alkohol (Ethanol) ist eines der effektivsten und breit wirksamsten Konservierungsmittel, das auch in der Naturkosmetik zugelassen ist. Ab einer Konzentration von etwa 15-20 % in einer wässrigen Formulierung wirkt er stark hemmend auf das Wachstum von Bakterien und Pilzen. Viele Naturkosmetik-Marken nutzen diese Eigenschaft, um ihre Produkte zu stabilisieren. Dies erklärt, warum „Alcohol“ oft weit oben in der INCI-Liste von Tonern, Seren oder leichten Fluiden aus dem Naturkosmetikbereich zu finden ist. Der Nachteil ist jedoch, dass eine solch hohe Konzentration für trockene oder empfindliche Hauttypen austrocknend und reizend wirken kann – ein direkter Zielkonflikt zwischen Konservierung und Hautverträglichkeit.
Ätherische Öle sind die zweite Säule der natürlichen Konservierung. Viele dieser hochkonzentrierten Pflanzenextrakte, wie Teebaumöl, Lavendelöl, Rosmarin- oder Thymianöl, besitzen von Natur aus starke antibakterielle und antimykotische Eigenschaften. Sie werden oft in Kombination eingesetzt (ein sogenannter „Hürden-Effekt“), um ein breiteres Spektrum an Keimen abzudecken. Der Nachteil hierbei ist das hohe allergene Potenzial. Ätherische Öle bestehen aus Dutzenden von Einzelkomponenten, von denen viele (z. B. Linalool, Limonene, Geraniol) als deklarationspflichtige Allergene eingestuft sind. Für Menschen mit empfindlicher Haut oder einer Neigung zu Allergien kann die zur Konservierung notwendige Konzentration dieser Öle zu einem ständigen Reizfaktor werden.
Zusätzlich nutzen Formulierer weitere Tricks: luftdichte Spender (Airless-Pumpspender), die den Kontakt mit Luft und Fingern minimieren, oder Formulierungen mit sehr niedrigem Wassergehalt. Wie Experten für kosmetische Formulierungen bestätigen, benötigen reine Ölprodukte oder Balsame oft gar keine Konservierung, da ohne Wasser kein mikrobielles Wachstum möglich ist. Das eigentliche Problemfeld sind und bleiben wasserbasierte Produkte wie Cremes und Lotionen. Die Naturkosmetik steht hier vor der Herausforderung, eine Balance zwischen effektiver Konservierung, Hautverträglichkeit und dem Verzicht auf synthetische Stoffe zu finden – ein Kompromiss, der nicht immer zugunsten der empfindlichsten Hauttypen ausfällt.
Warum ein pH-Wert von 5,5 für Ihre Haut überlebenswichtig ist?
Der leicht saure pH-Wert der Haut ist mehr als nur ein oberflächlicher Schutz; er ist der Dirigent eines komplexen Orchesters von biochemischen Prozessen, die für die Regeneration und den Zusammenhalt der Hautbarriere unerlässlich sind. Eine Abweichung von diesem optimalen Wert von etwa 5,5 legt lebenswichtige Funktionen lahm und beeinträchtigt die Fähigkeit der Haut, sich selbst zu reparieren.
Das Herzstück der Hautbarriere ist die äusserste Schicht, die Hornschicht (Stratum corneum). Man kann sie sich wie eine Ziegelsteinmauer vorstellen: Die „Ziegel“ sind die abgestorbenen Hautzellen (Korneozyten) und der „Mörtel“, der alles zusammenhält, besteht aus einer komplexen Mischung von Lipiden, hauptsächlich Ceramiden, Cholesterin und freien Fettsäuren. Dieser Lipidmörtel ist entscheidend, um Feuchtigkeit in der Haut zu halten und das Eindringen von Schadstoffen und Allergenen zu verhindern.
Die Produktion dieses Mörtels wird von spezifischen Enzymen gesteuert, und diese Enzyme arbeiten nur in einer sauren Umgebung effizient. Wird der pH-Wert der Haut durch alkalische Produkte (wie Seife) in den basischen Bereich verschoben, stellen diese Enzyme ihre Arbeit praktisch ein. Dies hat direkte und gravierende Folgen, die in der Forschung gut dokumentiert sind.
Fallbeispiel: Das Schweigen der Ceramid-Fabriken
Eine wissenschaftliche Untersuchung der Hautphysiologie hat gezeigt, dass Schlüsselenzyme wie die β-Glucocerebrosidase und die saure Sphingomyelinase, die für die Synthese von Ceramiden verantwortlich sind, ihr Aktivitätsoptimum bei einem pH-Wert um 5,0 haben. Steigt der pH-Wert in den neutralen oder alkalischen Bereich, sinkt ihre Aktivität dramatisch. Dies blockiert die Fähigkeit der Haut, ihren eigenen „Lipidmörtel“ zu produzieren und Risse in der Hautbarriere zu reparieren. Gleichzeitig verlangsamt ein hoher pH-Wert auch die natürliche, geordnete Abschuppung der Haut (Desquamation), was zu einem fahlen Teint und einer rauen Hautoberfläche führt. Die Aufrechterhaltung eines sauren pH-Wertes ist also eine direkte Voraussetzung für die Selbstheilungskräfte der Haut.
Ein pH-Wert von 5,5 ist somit keine willkürliche Zahl, sondern die betriebliche Voraussetzung für die Hautgesundheit auf zellulärer Ebene. Er sorgt dafür, dass die „Ceramid-Fabriken“ laufen, die Hautbarriere intakt bleibt und das Mikrobiom im Gleichgewicht ist. Jede Pflege-Routine sollte daher darauf abzielen, diesen lebenswichtigen sauren Zustand zu erhalten oder wiederherzustellen.
Das Wichtigste in Kürze
- Das grösste unmittelbare Risiko in der Kosmetik ist nicht ein hypothetisches chemisches Risiko, sondern die reale Gefahr der mikrobiellen Kontamination in schlecht konservierten Produkten.
- „Clean Beauty“ ist ein unregulierter Marketingbegriff. Die Sicherheit und Wirksamkeit eines Produkts hängen von seiner wissenschaftlich fundierten Formulierung ab, nicht von einer „No-Liste“.
- Funktionale Eigenschaften wie ein hautphysiologischer pH-Wert von 5,5 sind für die Gesundheit der Hautbarriere oft entscheidender als Labels wie „bio“ oder „natürlich“.
Kaputte Hautbarriere erkennen: Warum Ihre Haut brennt, egal was Sie auftragen?
Sie haben das Gefühl, Ihre Haut rebelliert? Selbst die einfachste Feuchtigkeitscreme oder sogar reines Wasser verursacht ein brennendes, stechendes Gefühl? Herzlichen Glückwunsch, Sie haben wahrscheinlich das Endstadium der Hautbarrierestörung erreicht. Dieser Zustand, bei dem die Haut auf fast alles mit Irritation reagiert, ist ein klares Alarmsignal. Es bedeutet, dass der schützende Lipidmörtel Ihrer Hornschicht so stark beschädigt ist, dass er seine Funktion nicht mehr erfüllen kann.
Wenn die Hautbarriere intakt ist, bildet sie eine robuste Dichtung, die die darunter liegenden, empfindlichen Strukturen und Nervenenden schützt. Ist diese Barriere jedoch „löchrig“ geworden – durch zu aggressive Reinigung, Produkte mit falschem pH-Wert oder ständige Reizung –, liegen diese Nervenenden quasi frei. Inhaltsstoffe, die normalerweise völlig harmlos sind und auf gesunder Haut keine Reaktion hervorrufen würden, können nun direkt mit diesen Nerven in Kontakt kommen und ein Schmerz- oder Brennsignal auslösen. Das ist der Grund, warum plötzlich selbst Produkte brennen, die Sie jahrelang gut vertragen haben.
Die Anzeichen einer geschädigten Barriere sind nicht immer so dramatisch wie ein brennendes Gefühl. Oft beginnt es schleichend mit Symptomen, die leicht zu übersehen sind. Dazu gehören eine anhaltende Dehydration, bei der die Haut sich trotz ständigem Eincremen trocken und gespannt anfühlt, weil sie die Feuchtigkeit nicht mehr halten kann. Auch eine plötzliche, unerklärliche Empfindlichkeit gegenüber zuvor gut vertragenen Produkten, anhaltende Rötungen, ein fahler Teint oder eine raue, schuppige Textur sind typische Warnzeichen. All diese Symptome deuten darauf hin, dass das empfindliche Gleichgewicht Ihrer Haut gestört ist und sofortige, gezielte Massnahmen erfordert.
Die Reparatur einer derart geschädigten Barriere erfordert Geduld und eine radikale Vereinfachung der Pflegeroutine. Der erste und wichtigste Schritt ist, die Haut in Ruhe zu lassen. Das bedeutet einen sofortigen Stopp aller potenziell reizenden Substanzen: keine Peelings, keine aktiven Wirkstoffe wie Vitamin C, Retinol oder starke Säuren. Die Routine sollte auf ein absolutes Minimum reduziert werden: ein milder, pH-neutraler Reiniger, eine minimalistische, parfümfreie Creme mit barrierestärkenden Inhaltsstoffen wie Ceramiden, Niacinamid oder Panthenol und tagsüber ein konsequenter Sonnenschutz, vorzugsweise auf mineralischer Basis.
Bewerten Sie Ihre Hautpflege von nun an nicht mehr nach Marketing-Versprechen, sondern nach wissenschaftlichen Fakten. Anstatt Inhaltsstoffe zu fürchten, lernen Sie, Formulierungen zu verstehen. Eine gesunde, widerstandsfähige Haut ist das Ergebnis von Wissen und einer intelligenten Produktauswahl, nicht von Angst und blinder Vermeidung.
Häufige Fragen zu Konservierungsstoffe und „Clean Beauty“
Warum brennt meine Haut sogar bei Kontakt mit Wasser?
Wenn die Hautbarriere stark geschädigt ist, sind die Nervenenden, die normalerweise durch eine schützende Lipidschicht abgeschirmt sind, freigelegt. Selbst eine neutrale Substanz wie Wasser kann dann diese empfindlichen Nerven reizen und ein Brennen oder Stechen auslösen, weil der natürliche Schutzfilm fehlt.
Was sind weniger offensichtliche Anzeichen für eine geschädigte Barriere?
Neben dem Brennen gibt es subtilere Zeichen. Dazu gehören anhaltende Dehydration, bei der die Haut trotz Cremes trocken bleibt, eine plötzliche Empfindlichkeit gegenüber Produkten, die Sie früher gut vertragen haben, oder eine diffuse, chronische Rötung, die nicht wegzugehen scheint.
Wie repariere ich eine kaputte Hautbarriere?
Der Schlüssel ist ein sofortiger „Reset“. Stoppen Sie alle aktiven und potenziell reizenden Inhaltsstoffe wie Säuren (AHA/BHA), Retinol und Vitamin C. Reduzieren Sie Ihre Routine auf das absolute Minimum: ein sanfter Reiniger mit einem pH-Wert von 5,5, eine reichhaltige, parfümfreie Reparaturcreme (mit Ceramiden, Panthenol oder Niacinamid) und tagsüber eine mineralische Sonnencreme.